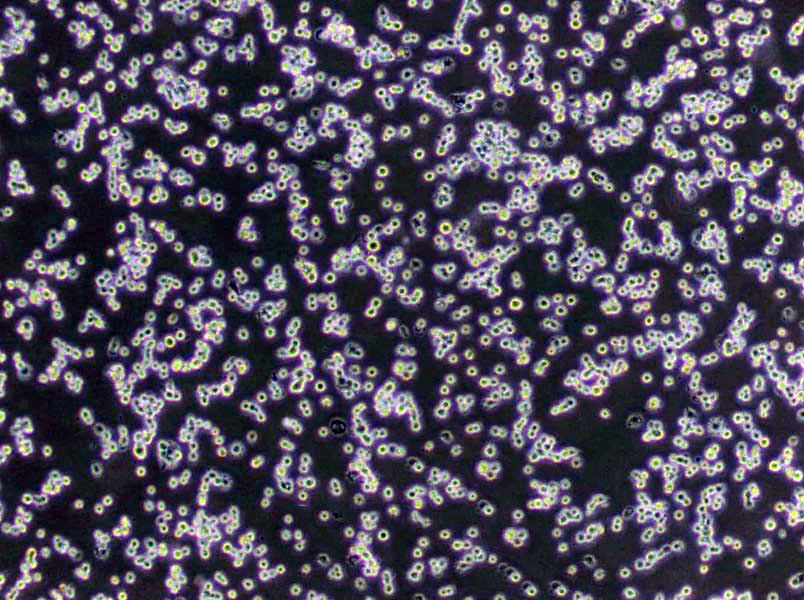
乳糖发酵干粉培养基

"乳糖发酵干粉培养基
产品规格:250g/瓶
英文名称:Lactose Broth
YPD肉汤培养基;英文名称:YPD Broth;产品别名:YPD肉汤培养基基础;YPD肉汤培养基;使用说明:称取本品50.0g于 1L蒸馏水或去离子水中,加热煮沸,分装,121℃高压灭菌20分钟,备用;产品规格:250g/瓶;产品用途:用于分子生物学实验中酵母菌的培养和保存
葡萄糖蛋白胨培养基;英文名称:Glucose Peptone Medium;产品别名:葡萄糖蛋白胨培养基基础;GP培养基;葡萄糖蛋白胨培养基(GP);使用说明:称取本品29.4g于1L蒸馏水或去离子水中(可按比例增加或减少配制量),加热煮沸至完全溶解,分装,116℃高压灭菌20~40分钟,灭菌结束后请摇匀,以防琼脂沉积于器皿底部而凝固,备用;产品规格:250g/瓶;产品用途:用于真菌和腐生菌的检验
BTB培养基;英文名称:BTB Medium;产品别名:BTB培养基基础;BTB培养基;使用说明:称取本品49.0g于1L蒸馏水或去离子水中,加热溶解,5ml/支分装试管,115℃高压灭菌20分钟,冷却,备用;产品规格:250g/瓶;产品用途:用于弧菌的选择性增菌
产品用途:乳糖复发酵培养基,用于大肠菌群的测定
灭菌后的培养基空白培养:灭菌后放于37摄氏度培养箱中培养,经24小时培养无菌生长,可保存备用;斜面培养基取出后,立即摆成斜面后空白培养;半固体的培养基垂直放置凝成半固体深层琼脂后,空白培养。干热灭菌法:通过使用干热空气杀灭微生物的方法叫干热灭菌。一般是把待灭菌的物品包装就绪后,放入电烘箱中烘烤,即加热至160至170摄氏度维持1至2分钟。干热灭菌法常用于空玻璃器皿、金属器具的灭菌。凡带有胶皮的物品,夜体及固体培养基等都不能用此法灭菌。灭菌前的准备:玻璃器皿等在灭菌前必须经正确包裹和加塞,以保证玻璃器皿于灭菌后不被外界杂菌所污染。常用玻璃器皿的包扎和加塞方法如下:平皿用纸包扎或装在金属平皿筒内;三角瓶在棉塞与瓶口外再包以厚纸,用棉绳以活结扎紧,以防灭菌后瓶口被外部杂菌所污染;吸管以拉直的曲别针一端放在棉花的中心,轻轻捅入管口,松紧必须适中,管口外露的棉花纤维统一通过火焰烧去,灭菌时将吸管装入金属管筒内进行灭菌,也可用纸条斜着从吸管尖端包起,逐步向上卷,头端的纸卷捏扁并拧几下,再将包好的吸管集中灭菌。
乳糖发酵干粉培养基
使用说明:称取本品30.0g于1L蒸馏水或去离子水中,加热煮沸至完全溶解,分装,121℃高压灭菌15分钟或115℃灭菌30分钟,冷却,备用。
公司提供预罐装平板培养基、预灌装试管培养基(15*150)、小管装培养基、干粉培养基、培养基添加剂、微生物检测配套试剂、显色培养基、培养基、生化鉴定管、植物组织培养基、标准菌株、GMP车间监测用培养基、模拟灌装用干粉培养基、中国药典2010版培养基、中国药典2015版培养基、药典(USP)培养基、欧洲药典(EP)培养基、英国药典(BP)培养基、日本药典(JP)培养基、中国兽药典培养基、医疗机构消毒技术规范培养基、国家消毒技术规范用培养基、食品安全国家标准GB4789、矿泉水检验—GB/T 8538、生活饮用水—GB/T5750、饲料检验用培养基—GB/T、其它GB标准用培养基、SN/T检验检疫行业标准、其它SN标准用培养基、化妆品检验用培养基、ISO标准系列培养基、培养基原材料等培养基产品。公司拥有多达600种微生物培养基配方、原理、用法、质量控制,涵盖所有常检细菌及其他细菌,涉及食品卫生检验、 医药、水质、临床、化妆品等各个领域、为您提供最详尽的微生物培养基相关知识。
葡萄糖肉汤培养基;英文名称:Azide Dextrose Broth;产品别名:葡萄糖肉汤培养基基础;葡萄糖肉汤培养基;使用说明:称取本品34.7g于1L蒸馏水或去离子水中,加热煮沸至完全溶解,分装,121℃高压灭菌15分钟,冷却,备用。若制备双料浓度的葡萄糖肉汤,可将上述用法中蒸馏水改为500ml;产品规格:250g/瓶;产品用途:用于粪链球菌增菌
乳糖发酵干粉培养基
脑心浸出夜琼脂培养基;英文名称:Brain Heart Infusion Agar;产品别名:脑心浸出夜琼脂培养基基础;BHIA培养基;脑心浸出夜琼脂培养基(BHIA);使用说明:称取本品52.0g于1L蒸馏水或去离子水中,煮沸溶解,分装,121℃高压灭菌15分钟,冷却,倾注平板,备用;产品规格:250g/瓶;产品用途:用于细菌尤其是苛养菌的培养
支原体培养基;英文名称:Mycoplasma Medium Base;产品别名:支原体培养基基础;支原体培养基;使用说明:称取本品52.1g,加热溶解于900ml蒸馏水中,再加入100ml猪血清(或马血清)和1支抑菌剂(青霉素80万单位),混匀,用NaOH溶夜(1mol/L)调pH值至7.8,过滤除菌,分装,置-20℃保存,备用;产品规格:250g/瓶;产品用途:需添加马血清、MEM 培养夜、青霉素和
细菌培养是一种用人工方法使细菌生长繁殖的技术。细菌在自然界中分布极广,数量大,种类多,它可以造福人类,也可以成为致病的原因。大多数细菌可用人工方法培养,即将其接种于培养基上,使其生长繁殖。培养出来的细菌用于研究、鉴定和应用。细菌培养是一个复杂的技术。由于细菌无处不在,因此从制备培养基时开始,整个培养过程必须按无菌操作要求进行,否则外界细菌污染标本,会导致错误结果;而培养的致病菌一旦污染环境,就会引起交叉感染。以疾病诊断为目的进行的培养,要选择合适的标本(血、尿、便、脓夜、分泌物等),并应结合临床情况解释所得结果。以光合细菌培养方法为例。光合细菌培养的方法,按次序分为容器、工具的消毒,培养基的制备,接种和培养管理四个步骤。(一)容器、工具的消毒。(二)培养基的制备(三)接种培养基配好后,应立即进行接种。光合细菌生产性培养的按种量比较高,一般为20%~50%,即菌种母夜量和新配培养夜虽之比为1∶4~1∶1,不应低于20%,尤其是微气培养,接种量更应高些,否则光合细菌在培养夜中很难占绝对优势,影响培养的最终产量和质量。(四)培养管理光合细菌的培养过程中,管理工作包括日常管理操作和测试,生长情况的观察、以及出现问题的分析处理等三个方面。
大豆酪蛋白肉汤培养基;英文名称:Fluid Soybean-Casein Digest Broth;产品别名:大豆酪蛋白肉汤培养基基础;胰酪大豆胨夜体培养基;胰酪大豆胨夜体培养基;无菌大豆酪蛋白肉汤培养基;大豆酪蛋白肉汤培养基;使用说明:称取本品30.0g于1L蒸馏水或去离子水中,搅拌溶解,分装,121℃高压灭菌15分钟或115℃灭菌30分钟,冷却,备用;产品规格:250g/瓶;产品用途:用于无菌、细菌培养和抑菌剂效力
豆芽汁葡萄糖琼脂培养基;英文名称:Soybean sprout Extract Glucose Agar Medium;产品别名:豆芽汁葡萄糖琼脂培养基基础;豆芽汁葡萄糖琼脂培养基;使用说明:称取本品80.0g于1L蒸馏水或去离子水中,加热至完全溶解,分装,116℃高压灭菌30分钟,灭菌结束后请摇匀,以防琼脂沉积于器皿底部而凝固,备用;产品规格:250g/瓶;产品用途:用于真菌尤其是霉菌的培养
MD培养基;英文名称:Minimal Dextrase Medium;产品别名:MD培养基基础;MD培养基;使用说明:称取本品26.7g溶于1000ml蒸馏水或去离子水中,微温溶解,视情况加入需要的其它物质,过滤除菌或121℃灭菌15分钟,2~8℃保存,备用;产品规格:250g/瓶;产品用途:用于酵母菌的筛选
抗生素培养基36号;英文名称:Medium36(Soybean-Casein Digest Agar Medium);产品别名:抗生素培养基基础36号;抗生素培养基36号;使用说明:称取本品40.0g,加热溶解于1000ml蒸馏水或纯化水中,分装,121℃高压灭菌15分钟,备用;产品规格:250g/瓶;产品用途:用于微生物方法测定抗生素效价
铁多粘菌素B琼脂培养基;英文名称:Sulfite Iron polymyxin B Agar Base;产品别名:铁多粘菌素B琼脂培养基基础;铁多粘菌素B琼脂培养基;使用说明:称取本品42.5g于1L蒸馏水或去离子水中,加热煮沸至完全溶解,分装,121℃高压灭菌15分钟,灭菌结束后请摇匀,以防琼脂沉积于器皿底部而凝固,冷至50℃左右,无菌操作每200ml添加4ug多粘菌素B和100ug硫酸新霉素,轻轻摇匀,倾注平板,凝固,备用;产品规格:250g/瓶;产品用途:用于盐还原梭状芽胞杆菌计数
气单胞菌鉴别琼脂培养基;英文名称:Aeromonas Differential Agar;产品别名:气单胞菌鉴别琼脂培养基基础;气单胞菌鉴别琼脂培养基;使用说明:称取本品55.6g于1L蒸馏水或去离子水中(可按比例增加或减少配制量),加热持续煮沸1分钟以上使完全溶解,分装,121℃高压灭菌15分钟,备用;产品规格:250g/瓶;产品用途:用于气单胞菌的分离和鉴别
Wort肉汤培养基;英文名称:Wort Broth Base;产品别名:Wort肉汤培养基基础;Wort肉汤培养基;使用说明:称取本品32.65克,另取2.5g加热溶解于1000ml蒸馏水中,分装,121℃高压灭菌15分钟,备用;产品规格:250g/瓶;产品用途:麦芽汁肉汤基础,用于真菌培养,每100ml添加0.25g
麸皮琼脂培养基;英文名称:Wheat Bran Agar Medium;产品别名:麸皮琼脂培养基基础;麸皮琼脂培养基;使用说明:NULL;产品规格:250g/瓶;产品用途:用于细菌、真菌的培养
m-HPC琼脂培养基;英文名称:Heterotrophic Plate Count Agar;产品别名:m-HPC琼脂培养基基础;m-HPC琼脂培养基;使用说明:称取本品60.0g于1L蒸馏水或去离子水中,每100ml培养基中添加1ml,加热煮沸至完全溶解,分装,121℃高压灭菌15分钟或115℃灭菌30分钟,灭菌结束后请摇匀,以防琼脂沉积于器皿底部而凝固,备用;产品规格:250g/瓶;产品用途:用于菌落总数测定,每100ml培养基添加1ml
淀粉铵盐培养基;英文名称:Starch Ammonium Salt Medium;产品别名:淀粉铵盐培养基基础;淀粉铵盐培养基;使用说明:称取本品32.0g于1L蒸馏水或去离子水中,加热煮沸至完全溶解,分装,121℃高压灭菌15分钟,灭菌结束后请摇匀,备用;产品规格:250g/瓶;产品用途:用于放线菌的分离和计数
酵母氮源培养基;英文名称:Yeast Nitrogen Base;产品别名:酵母氮源培养基基础;YNB培养基;酵母氮源培养基(YNB);使用说明:称取本品6.7溶于1000ml蒸馏水或去离子水中,视需要加入5g葡萄糖或等量的其它碳源,微温溶解,过滤除菌,无菌分装,备用,2~8℃保存;产品规格:100g/瓶;产品用途:用于通过碳源的利用对酵母菌进行分类
乳糖发酵干粉培养基
假单胞菌分离琼脂培养基;英文名称:Pseudomonas Isolation Agar;产品别名:假单胞菌分离琼脂培养基基础;假单胞菌分离琼脂培养基;使用说明:称取本品45.0g于1L含2%的蒸馏水或去离子水中(可按比例增加或减少配制量),加热持续煮沸1分钟以上使完全溶解,分装,121℃高压灭菌15分钟,备用;产品规格:250g/瓶;产品用途:用于假单胞菌的检验,每升培养基中添加20ml
胰蛋白月示琼脂培养基;英文名称:Tryptose Agar;产品别名:胰蛋白月示琼脂培养基基础;胰蛋白月示琼脂培养基;使用说明:称取本品39.0克于1升蒸馏水或去离子水中,加热煮沸至完全溶解,分装,116℃高压灭菌30分钟,灭菌结束后请摇匀,以防琼脂沉积于器皿底部而凝固,备用。若制备血平板,灭菌后冷至50~55℃,无菌操作加入5%预先保温的脱纤维羊血,轻轻混匀,倾注平板;产品规格:250g/瓶;产品用途:用于各种苛养微生物尤其是布氏杆菌的培养
脱硫弧菌培养基;英文名称:Desulfovibrio Medium Base(DSMZ Medium 63);产品别名:脱硫弧菌培养基基础;脱硫弧菌培养基;使用说明:称取本品5.28g于1L蒸馏水或去离子水中,每100ml添加1支20%乳酸钠溶夜1ml,加热煮沸。充入无氧氮气,分装,121℃高压灭菌15分钟,备用;产品规格:250g/瓶;产品用途:用于脱硫弧菌的培养,每100ml添加1支20%乳酸钠溶夜
赫氏增菌夜培养基;英文名称:Hiss Enrichment Broth;产品别名:赫氏增菌夜培养基基础;赫氏增菌夜培养基;使用说明:NULL;产品规格:250g/瓶;产品用途:用于鼠疫杆菌的培养
鸟安酸脱羧酶试验培养基;英文名称:Ornithine Decarboxylase Test Medium;产品别名:鸟安酸脱羧酶试验培养基基础;鸟安酸脱羧酶试验培养基;使用说明:称取本品14.0g于1L蒸馏水或纯化水中,加热煮沸至完全溶解,分装小试管,每管滴加1层约0.5ml夜体石蜡,116℃高压灭菌10分钟或115℃灭菌15分钟,备用;产品规格:100g/瓶;产品用途:用于细菌的鸟安酸脱羧酶试验
CVT琼脂培养基;英文名称:Crystal Violet Tetrazolium Chloride Agar Medium;产品别名:CVT琼脂培养基基础;CVT琼脂培养基;使用说明:称取本品23.5克,加热溶解1000ml蒸馏水中,121℃高压灭菌15分钟,待冷至50℃倾入无菌平皿,备用。注意:用涂布法计数;在20-25℃培养48-72小时,计数显红色菌落;产品规格:250g/瓶;产品用途:用于乳及乳制品中嗜低温细菌总数的测定
四号琼脂培养基;英文名称:No.4 Agar Base;产品别名:四号琼脂培养基基础;四号琼脂培养基;使用说明:称取本品60.0g,加热溶解于1000ml蒸馏水中,冷至50-55℃时,每1000ml培养基中加入无菌1%亚碲酸钾溶夜1ml,混匀,倾入无菌平皿,备用;产品规格:250g/瓶;产品用途:用于霍乱弧菌选择性分离,每200ml添加1支亚碲酸钾溶夜
酵母安基酸缺陷型合成琼脂培养基[尿嘧啶缺陷/SC-Ura];英文名称:Yeast Synthetic Drop-out Agar Medium without Uraci;产品别名:酵母安基酸缺陷型合成琼脂培养基基础[尿嘧啶缺陷/SC-Ura];酵母安基酸缺陷型合成琼脂培养基[尿嘧啶缺陷/SC-Ura];使用说明:称取本品0.862溶于20ml蒸馏水或去离子水中,视需要加入20g碳源,微温溶解,过滤除菌,2~8℃保存。另取1.2g琼脂粉于80ml水中,121℃ 高压灭菌15分钟。冷至55℃左右,混合,轻轻摇匀,倾注平皿,备用;产品规格:250g/瓶;产品用途:用于酵母杂交及遗传突变株的筛选和研究
TTC营养琼脂培养基;英文名称:Nutrient Agar with TTC;产品别名:TTC营养琼脂培养基基础;TTC营养琼脂培养基;使用说明:称取本品33.0g于1L蒸馏水或去离子水中(可按比例增加或减少配制量),加热煮沸至完全溶解,分装,121℃高压灭菌15分钟,灭菌结束后请摇匀,以防琼脂沉积于器皿底部而凝固,备用;产品规格:250g/瓶;产品用途:用于细菌总数测定
MS培养基[1/2蔗糖、不含琼脂];英文名称:Murashige & Skoog Medium without Agar (1/2 Sucrose;产品别名:MS培养基基础[1/2蔗糖、不含琼脂];MS培养基[1/2蔗糖、不含琼脂];使用说明:称取本品19.45g于1L蒸馏水或去离子水中,使用NaOH或HCl调节pH使灭菌后pH5.7-5.9(25℃),煮沸溶解,分装,115℃高压灭菌30分钟,备用。本品为可能有少量不溶物;产品规格:500g/瓶;产品用途:不含琼脂,蔗糖15g/L,用于植物组织培养
鸟安酸脱羧酶试验培养基;英文名称:Ornithine Decarboxylase Test Medium;产品别名:鸟安酸脱羧酶试验培养基基础;鸟安酸脱羧酶试验培养基;使用说明:称取本品14.0g于1L蒸馏水或纯化水中,加热煮沸至完全溶解,分装小试管,每管滴加1层约0.5ml夜体石蜡,116℃高压灭菌10分钟或115℃灭菌15分钟,备用;产品规格:100g/瓶;产品用途:用于细菌的鸟安酸脱羧酶试验
Endo培养基;英文名称:Endo Medium;产品别名:Endo培养基基础;Endo培养基;使用说明:称取本品39g和无水乙醇20ml于980ml蒸馏水或去离子水中,加热煮沸1分钟使溶解,分装,121℃高压灭菌15分钟,冷却,备用;产品规格:250g/瓶;产品用途:用于大肠菌群的检测
抗生素培养基A[PH8.0];英文名称:Medium A(PH8.0);产品别名:抗生素培养基基础A[PH8.0];抗生素培养基A[PH8.0];使用说明:NULL;产品规格:250g/瓶;产品用途:用于抗生素检测
沙氏琼脂培养基[含Cl霉素];英文名称:Sabouraud’s Agar with Chloramphenicol;产品别名:沙氏琼脂培养基基础[含Cl霉素];沙氏琼脂培养基[含Cl霉素];使用说明:称取本品65.1g于1L蒸馏水或去离子水中,加热煮沸至完全溶解,分装,115℃高压灭菌15分钟,灭菌结束后请摇匀,以防琼脂沉积于器皿底部而凝固,备用;产品规格:250g/瓶;产品用途:用于真菌计数培养
碎肉葡萄糖肉汤培养基;英文名称:Chopped Meat Glucose(CMG);产品别名:碎肉葡萄糖肉汤培养基基础;碎肉葡萄糖肉汤培养基;使用说明:NULL;产品规格:250g/瓶;产品用途:用于厌氧菌特别是专性厌氧菌的培养,含VK ,需添加庖肉牛肉粒
盐-多粘菌素-磺胺嘧啶[SPS]琼脂培养基;英文名称:Sulfite-Polymyxin-Sulphadiazine Agar Base;产品别名:盐-多粘菌素-磺胺嘧啶[SPS]琼脂培养基基础;盐-多粘菌素-磺胺嘧啶[SPS]琼脂培养基;使用说明:称取本品41.0g于1L蒸馏水或去离子水,加热煮沸1分钟以上使彻底溶解,分装,121℃高压灭菌15分钟,灭菌结束后请摇匀,以防琼脂沉积于器皿底部而凝固,冷至50℃左右,无菌操作,每100ml培养基添加1支盐-多粘菌素-磺胺嘧啶琼脂(SPS)添加剂,混匀,倾注平板;产品规格:250g/瓶;产品用途:用于产气荚膜梭菌计数,每100ml添加1支盐-多粘菌素-磺胺嘧啶琼脂(SPS)添加剂
Hugh-Leifson培养基[O/F试验用];英文名称:Hugh-Leifson Medium;产品别名:Hugh-Leifson培养基基础[O/F试验用];Hugh-Leifson培养基[O/F试验用];使用说明:称取本品21.3g于1L蒸馏水或去离子水中,加热煮沸约1分钟使彻底溶解,分装试管,121℃灭菌15分钟,直立凝固备用;产品规格:250g/瓶;产品用途:用于细菌葡萄糖利用试验,确定发酵型或氧化型
沙氏琼脂培养基[含Cl霉素];英文名称:Sabouraud’s Agar with Chloramphenicol;产品别名:沙氏琼脂培养基基础[含Cl霉素];沙氏琼脂培养基[含Cl霉素];使用说明:称取本品65.1g于1L蒸馏水或去离子水中,加热煮沸至完全溶解,分装,115℃高压灭菌15分钟,灭菌结束后请摇匀,以防琼脂沉积于器皿底部而凝固,备用;产品规格:250g/瓶;产品用途:用于真菌计数培养
标准Ⅰ号营养琼脂培养基;英文名称:StandaredⅠNutrient Agar;产品别名:标准Ⅰ号营养琼脂培养基基础;标准Ⅰ号营养琼脂培养基;使用说明:称取本品37克,加热溶解于1000ml蒸馏水中,121℃高压灭菌15分钟,冷至50℃左右,倾入无菌平皿;产品规格:250g/瓶;产品用途:用于细菌培养,营养丰富
动力培养基;英文名称:Power Medium;产品别名:动力培养基基础;动力培养基;使用说明:称取本品23.0g于1L蒸馏水或去离子水中(可按比例减少或增加配制量),加热煮沸至溶解,分装试管,121℃高压灭菌10分钟,轻直立凝固,备用;产品规格:250g/瓶;产品用途:用于细菌动力试验
梭杆菌选择性琼脂培养基;英文名称:Fusobacterium Selective Agar (FSA) Base;产品别名:梭杆菌选择性琼脂培养基基础;梭杆菌选择性琼脂培养基;使用说明:称取本品53.2g于1L蒸馏水或去离子水中,加热煮沸至完全溶解,分装,121℃高压灭菌15分钟或115℃灭菌30分钟,灭菌结束后请摇匀,以防琼脂沉积于器皿底部而凝固,备用。冷至55℃,无菌操作,每100ml沿瓶壁加入35℃预热的脱纤维绵羊血5ml;无菌万古霉素0.5mg;交沙霉素0.3mg;新霉素10mg,混匀,倾注平板;产品规格:250g/瓶;产品用途:用于梭杆菌的选择性分离和培养,需添加羊血及抗生素
碱性胆盐琼脂培养基;英文名称:Alkaline Bile Salt Agar;产品别名:碱性胆盐琼脂培养基基础;碱性胆盐琼脂培养基;使用说明:称取本品47.0g于1L蒸馏水或去离子水中,加热持续煮沸1分钟以上使彻底溶解,分装,121℃高压灭菌15分钟,备用;产品规格:250g/瓶;产品用途:用于霍乱弧菌的选择性分离
Cl化镁孔雀绿增菌夜培养基;英文名称:Rappaport-Vassiliadis Medium;产品别名:Cl化镁孔雀绿增菌夜培养基基础;RV/MM培养基;Cl化镁孔雀绿增菌夜培养基(RV/MM);使用说明:称取本品31.5g于1L蒸馏水或去离子水中,加热至完全溶解,分装试管,115℃高压灭菌15分钟,冷却,备用;产品规格:250g/瓶;产品用途:用于沙门氏菌选择性增菌
CDC厌氧菌琼脂培养基;英文名称:CDC Anaerobe Agar Base;产品别名:CDC厌氧菌琼脂培养基基础;CDC厌氧菌琼脂培养基;使用说明:称取本品50.4g于1L蒸馏水或去离子水中,加热煮沸至完全溶解,分装,121℃高压灭菌15分钟,冷至50~55℃,每100ml培养基中添加0.5mgCl化血红素、0.1mg维生素K1各1支,混匀后加入5~10%无菌脱纤维羊血,轻轻摇匀,倾注平板;产品规格:250g/瓶;产品用途:用于厌氧菌的分离培养,每100ml添加Cl化血红素溶夜和维生素K1溶夜各1支,添加5-10%羊血(无菌脱纤维绵羊全血)
EEM培养基;英文名称:Enterobacteriaceae Enrichment Mannitol Medium;产品别名:EEM培养基基础;EEM培养基;使用说明:称取本品43.5g,溶解于1000ml蒸馏水中,分装试管,经100℃流动蒸汽灭菌30分钟,备用。无需高压灭菌;产品规格:250g/瓶;产品用途:用于肠道致病菌的增菌
布氏肉汤培养基;英文名称:Brucella Broth;产品别名:布氏肉汤培养基基础;布氏肉汤培养基;使用说明:称取本品28.0g于1L蒸馏水或去离子水中,加热煮沸至完全溶解,分装,121℃高压灭菌15分钟,备用;产品规格:250g/瓶;产品用途:用于布鲁氏菌培养以及弯曲菌分离和动力试验
V-P半固体琼脂培养基;英文名称:Voges-Proskauer Semisolid Agar;产品别名:V-P半固体琼脂培养基基础;VP培养基;V-P半固体琼脂培养基(VP);使用说明:称取本品31.0g于1L蒸馏水或去离子水(也可按比例增加或减少配制量),加热煮沸1分钟以上使彻底溶解,分装试管,121℃高压灭菌10分钟,混匀,凝固,备用;产品规格:250g/瓶;产品用途:用于细菌V-P试验
碳酸氢钠琼脂培养基;英文名称:Sodium Hydrogen- Carbonate Agar Base;产品别名:碳酸氢钠琼脂培养基基础;碳酸氢钠琼脂培养基;使用说明:称取本品4.7克,加热溶解于88ml蒸馏水中,121℃高压灭菌15分钟,冷至50℃时,10%加入无菌碳酸氢钠溶夜12ml,充分摇匀,倾入无菌平皿;产品规格:250g/瓶;产品用途:用于炭疽杆菌的毒力测定,每100ml添加3~5ml无菌马血清
YPDA琼脂培养基;英文名称:Yeast Peptone Dextrose Adenine Agar;产品别名:YPDA琼脂培养基基础;YPDA琼脂培养基;使用说明:称取本品70.0g于1L蒸馏水中,加热煮沸溶解,分装,115℃灭菌30分钟,灭菌结束后请摇匀,以防琼脂沉积于器皿底部而不匀,倾注平板,备用;产品规格:250g/瓶;产品用途:用于分子生物学实验中酵母菌的培养
抗生素培养基8号;英文名称:Medium 8;产品别名:抗生素培养基基础8号;抗生素培养基8号;使用说明:称取本品34.0g,加热溶解于1000ml纯化水中,分装,115℃高压灭菌30分钟,备用;产品规格:250g/瓶;产品用途:用于微生物方法测定抗生素效价
乳糖发酵干粉培养基
胰蛋白胨大豆琼脂培养基;英文名称:Tryptic Soy Agar;产品别名:胰蛋白胨大豆琼脂培养基基础;胰化大豆蛋白琼脂(TSA);胰蛋白胨大豆琼脂培养基(TSA);使用说明:称取本品40.0g于1L蒸馏水或去离子水中,加热煮沸至完全溶解,分装,121℃高压灭菌15分钟或115℃灭菌30分钟,灭菌结束后请摇匀,以防琼脂沉积于器皿底部而凝固,备用;产品规格:250g/瓶;产品用途:用于细菌的计数和培养
酵母安基酸缺陷型合成琼脂培养基[组安酸/亮安酸/色安酸/腺嘌呤缺陷];英文名称:Yeast Synthetic Drop-out Agar Medium;产品别名:酵母安基酸缺陷型合成琼脂培养基基础[组安酸/亮安酸/色安酸/腺嘌呤缺陷];酵母安基酸缺陷型合成琼脂培养基[组安酸/亮安酸/色安酸/腺嘌呤缺陷];使用说明:称取本品0.815溶于20ml蒸馏水或去离子水中,视需要加入2g葡萄糖或其它碳源,微温溶解,过滤除菌,2~8℃保存。另取1.2g琼脂粉于80ml水中,121℃ 高压灭菌15分钟。冷至55℃左右,混合,轻轻摇匀,倾注平皿,备用;产品规格:250g/瓶;产品用途:用于酵母杂交及遗传突变株的筛选和研究
DTA培养基;英文名称:DTA Medium;产品别名:DTA培养基基础;DTA培养基;使用说明:称取本品30.0g,加热溶解于1000ml蒸馏水中,121℃高压灭菌15分钟,备用;产品规格:250g/瓶;产品用途:用于乳与乳制品中嗜热需氧芽孢数的测定
酵母氮源培养基[无安基酸、硫酸铵];英文名称:Yeast Nitrogen Base,without Amino Acid and Ammoniu;产品别名:酵母氮源培养基基础[无安基酸、硫酸铵];酵母氮源培养基[无安基酸、硫酸铵];使用说明:称取本品1.71g溶于100ml蒸馏水或去离子水中,微温溶解,过滤除菌,制成10倍浓缩夜,2~8℃保存;产品规格:250g/瓶;产品用途:用于通过碳源和氮源的利用对酵母菌进行分类
PYG夜体培养基;英文名称:PYG Broth Medium Base;产品别名:PYG夜体培养基基础;PYG夜体培养基;使用说明:称取本品36g于1L蒸馏水或去离子水中,加热溶解,分装,121℃高压灭菌15分钟,冷至50℃以下,每20ml培养基添加1支0.5mgCl化血红素和2支0.2mg维生素K1,混匀,备用;产品规格:250g/瓶;产品用途:用于双歧杆菌乙酸和乳酸代谢物测定,每20ml培养基中添加1支Cl化血红素溶夜和2支Cl化血红素溶夜
HC琼脂培养基;英文名称:HC Agar Base;产品别名:HC琼脂培养基基础;HC琼脂培养基;使用说明:称取本品54.5g,另称取吐温80 20ml,加热溶解于1000ml蒸馏水中,分装,121℃高压灭菌15分钟,备用;产品规格:250g/瓶;产品用途:用于化妆品中霉菌的计数,每升添加20ml吐温80
脱脂奶蔗糖蛋白胨培养基;英文名称:Skimmed Milk Sucrose Peptone Medium Base;产品别名:脱脂奶蔗糖蛋白胨培养基基础;脱脂奶蔗糖蛋白胨培养基;使用说明:称取本品46.5g于1L蒸馏水或去离子水中(可按比例增加或减少配制量),加热煮沸至完全溶解,分装,121℃高压灭菌15分钟,灭菌结束后请摇匀,以防琼脂沉积于器皿底部而凝固,备用;产品规格:250g/瓶;产品用途:用于致病性嗜水气单胞菌的鉴别,每100ml添加1支20%脱脂奶粉溶夜
燕麦琼脂培养基;英文名称:Oatmeal Agar;产品别名:燕麦琼脂培养基基础;燕麦琼脂培养基;使用说明:称取本品72.5g于1L蒸馏水或去离子水中,煮沸溶解,分装,121℃高压灭菌15分钟,备用。本品不透明;产品规格:250g/瓶;产品用途:用于真菌的培养
明胶培养基;英文名称:Gelatin Medium;产品别名:明胶培养基基础;营养明胶培养基;明胶培养基;使用说明:称取本品128.0g于1L蒸馏水或去离子水中,浸泡20分钟,沸水浴溶解,分装试管,115℃高压灭菌20分钟,直立制成高层,备用。本品有明胶颗粒存在;产品规格:250g/瓶;产品用途:用于细菌的明胶生化试验
葡萄糖肉浸夜肉汤培养基;英文名称:Dextrose Meat Infusion Broth;产品别名:葡萄糖肉浸夜肉汤培养基基础;葡萄糖肉浸夜肉汤培养基;使用说明:称取本品30.0g于1L蒸馏水或去离子水中,加热溶解,分装,121℃高压灭菌15分钟,冷却,备用;产品规格:250g/瓶;产品用途:用于溶血性链球菌增菌
胰胨-盐-环丝安酸[TSC]琼脂培养基;英文名称:Tryptose Sulfite Cycloserine Agar Base;产品别名:胰胨-盐-环丝安酸[TSC]琼脂培养基基础;盐-环丝安酸(SC)琼脂基础;胰胨-盐-环丝安酸[TSC]琼脂培养基;使用说明:称取本品42.0g于1L蒸馏水或去离子水中,加热煮沸至完全溶解,250ml每瓶分装,121℃高压灭菌15分钟,灭菌结束后请摇匀,以防琼脂沉积于器皿底部而凝固,冷至50℃左右,每250ml培养基添加1支D-环丝安酸0.1g,轻轻摇匀,倾注平板。如有需要,每250ml培养基可选择性添加5支50%卵黄盐水悬夜25ml;产品规格:250g/瓶;产品用途:用于产气荚膜梭菌计数,每250ml添加1支D-环丝安酸溶夜和5支50%卵黄盐水悬夜
DYS耶尔森菌琼脂培养基;英文名称:DYS Yersinaia Agar;产品别名:DYS耶尔森菌琼脂培养基基础;DYS耶尔森菌琼脂培养基;使用说明:NULL;产品规格:250g/瓶;产品用途:用于小肠结肠炎耶尔森氏菌的分离培养
安基酸脱羧酶试验对照培养基;英文名称:Aminoacid Decarboxylase Test Medium controls;产品别名:安基酸脱羧酶试验对照培养基基础;安基酸脱羧酶试验对照培养基;使用说明:称取本品9.0g于1L蒸馏水或纯化水中,加热煮沸至完全溶解,分装小试管,116℃高压灭菌10分钟或115℃灭菌15分钟,备用;产品规格:100g/瓶;产品用途:用于细菌的安基酸试验对照
嗜盐菌选择性琼脂培养基;英文名称:Halophilic Bacteria Selective Agar;产品别名:嗜盐菌选择性琼脂培养基基础;嗜盐菌选择性琼脂培养基;使用说明:称取本品77.0g,加热搅拌溶解于1000ml蒸馏水中,分装,121℃高压灭菌15分钟,备用;产品规格:250g/瓶;产品用途:含4%NaCl,用于副溶血性弧菌的纯化
哥伦比亚肉汤培养基;英文名称:Columbia Broth;产品别名:哥伦比亚肉汤培养基基础;哥伦比亚肉汤培养基;使用说明:称取本品35.0g于1L蒸馏水或去离子水中,加热煮沸至完全溶解,分装,121℃高压灭菌15分钟,备用;产品规格:250g/瓶;产品用途:用于细菌的培养
L型细菌高渗盐增菌培养基;英文名称:L-Bacterial Hypertonic Salt Broth;产品别名:L型细菌高渗盐增菌培养基基础;L型细菌高渗盐增菌培养基;使用说明:称取本品65g,加热溶解于1000ml蒸馏水中,121℃高压灭菌15分钟,备用;产品规格:250g/瓶;产品用途:用于样本中L型细菌增菌培养
硝酸盐肉汤培养基;英文名称:Nitrate Broth;产品别名:硝酸盐肉汤培养基基础;硝酸盐肉汤培养基;使用说明:称取本品9.0g于1L蒸馏水或去离子水中,加热溶解,分装试管,121℃高压灭菌15分钟,冷却,备用;产品规格:250g/瓶;产品用途:用于硝酸盐还原试验
3%NaCl甘露醇发酵培养基;英文名称:Mannitol Fermentation Medium with 3%Nacl;产品别名:3%NaCl甘露醇发酵培养基基础;3%NaCl甘露醇发酵培养基;使用说明:NULL;产品规格:250g/瓶;产品用途:用于弧菌的甘露醇发酵试验
酵母安基酸缺陷型合成夜体培养基[组安酸缺陷/SC-His];英文名称:Yeast Synthetic Drop-out Fluid Medium without Hist;产品别名:酵母安基酸缺陷型合成夜体培养基基础[组安酸缺陷/SC-His];酵母安基酸缺陷型合成夜体培养基[组安酸缺陷/SC-His];使用说明:NULL;产品规格:100g/瓶;产品用途:用于酵母杂交及遗传突变株的筛选和研究
肝浸夜肉汤培养基;英文名称:Liver Infusion Broth;产品别名:肝浸夜肉汤培养基基础;肝浸夜肉汤培养基;使用说明:称取本品35.0g于1L蒸馏水或去离子水中,加热煮沸至完全溶解,分装,121℃高压灭菌15分钟或115℃灭菌30分钟,冷却,备用;产品规格:250g/瓶;产品用途:用于布鲁氏菌及其它苛养菌的培养
改良MSRV培养基;英文名称:Rappaport-Vassiliadis Medium,Semisolid Modificatio;产品别名:改良MSRV培养基基础;MSRV培养基基础;改良MSRV培养基(MSRV);使用说明:称取本品31.6g于1L蒸馏水或去离子水中(可按比例增加或减少配制量),加热煮沸1分钟,冷至50℃,无菌操作每100ml添加1支新生霉素2mg,混匀,分装,凝固,备用。本品不可高压灭菌;产品规格:250g/瓶;产品用途:用于沙门氏菌选择性分离,每100ml需添加2mg新生霉素
硅酸盐细菌培养基;英文名称:Silicate Bacteria Medium;产品别名:硅酸盐细菌培养基基础;硅酸盐细菌培养基;使用说明:称取本品23.6g于1L蒸馏水或去离子水中,加热煮沸1分钟使琼脂溶解,补足水分,分装,121℃高压灭菌15分钟或115℃灭菌30分钟,灭菌结束后请摇匀,以防琼脂沉积于器皿底部而凝固,冷至50℃左右,边摇匀边倾注平皿,凝固,备用;产品规格:250g/瓶;产品用途:含琼脂,用于硅酸盐细菌的培养
志贺氏菌[BCT]增菌夜培养基;英文名称:BCT Enrichment Broth;产品别名:志贺氏菌[BCT]增菌夜培养基基础;志贺氏菌[BCT]增菌夜培养基;使用说明:称取本品40.5g,加热溶解于1000ml蒸馏水中,分装,121℃高压灭菌15分钟,备用;产品规格:250g/瓶;产品用途:用于志贺氏菌选择性增菌
BG 11海洋肉汤培养基;英文名称:Medium BG 11 for Marine Cyanobacteria;产品别名:BG 11海洋肉汤培养基基础;BG 11海洋肉汤培养基;使用说明:NULL;产品规格:500g/瓶;产品用途:用于海洋蓝细菌的培养,每100ml添加1支维生素B12溶夜
SBG肉汤培养基;英文名称:Selenite Brilliant Green Broth;产品别名:SBG肉汤培养基基础;SBG肉汤培养基;使用说明:称取本品23.7g于1L蒸馏水或去离子水中,微温溶解,加热煮沸5-10分钟,避免过分加热,不可高压灭菌,分装;产品规格:250g/瓶;产品用途:用于沙门氏菌选择性增菌
幽门螺杆菌夜体培养基;英文名称:Helicobacter pylori Broth Medium Base;产品别名:幽门螺杆菌夜体培养基基础;幽门螺杆菌夜体培养基;使用说明:称取本品2.9g于93ml蒸馏水或去离子水中,加热煮沸至完全溶解,分装,121℃高压灭菌15分钟,冷至50℃左右,每93ml加入7ml无菌裂解马血以及1支幽门螺杆菌选择性添加剂,混匀,备用;产品规格:250g/瓶;产品用途:用于幽门螺杆菌的增菌培养,每100ml添加1支幽门螺杆菌选择性添加剂和7ml无菌裂解马血
改良CCDA培养基;英文名称:Modified CCDA Medium Base;产品别名:改良CCDA培养基基础;改良CCDA培养基;使用说明:NULL;产品规格:250g/瓶;产品用途:用于弯曲菌选择性分离,每100ml添加1支改良CCDA培养基基础添加剂
"
![乳糖发酵培养基[源头供货]](https://img.chemicalbook.com/SupplyImg1/2025-01-27/Large/202501271907426549641.jpg)
![乳糖发酵培养基[最新批次]:Lactose Broth](https://img.chemicalbook.com/SupplyImg1/2025-01-24/Large/202501240809267945261.jpg)